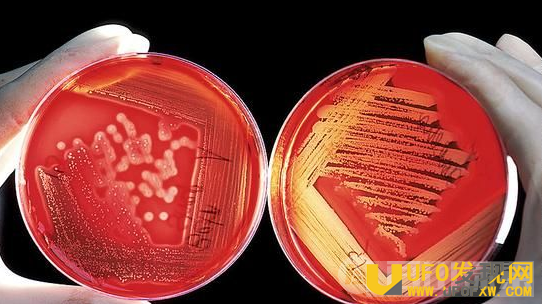

传说中“返老还童”技术成功,人类脐带血中的一种蛋白质可是人年轻
不久前,有研究显示,人类脐带血中的一种蛋白质可以活化年老小鼠的海马体,增强年老小鼠的认知功能。利用血液来进行抗衰老研究,这不禁让我们想起之前风靡一时的“吸血鬼疗法”。然而,年轻血液真的有“返老还童”的作用吗?
回溯
“抗衰老”研究经久不衰
回溯一下,近年来能够跻身于“最离奇的科学报告”的研究,非“吸血鬼疗法”莫属。有研究者通过“给老年小鼠输入年轻小鼠血液”的动物实验,发现可以改善老年小鼠的记忆和学习能力,使其变得年轻。如此骇人听闻的研究结果,很容易让人联想到电影大片中的吸血鬼,在传说中,吸血鬼们就是通过吸食血液维持生命并保持年轻的。

随后,有更多的研究和报道指出,这种“吸血鬼”式的抗衰老研究并不是近几年才兴起的。早在几十年前,就有一种名为“异种共生”的试验,试图在年老动物和年轻动物之间建立连接,实现体液循环。“抗衰老”的命题之所以能够经久不衰,想必也与我们人类希望永葆青春的夙愿有关。近几年来,不断有科学家试图找到年轻血液实现“返老还童”的特定机理和因素。在去年,更有美国一间初创的研究公司宣布将启动首例临床试验,以检验年轻血液抗衰老的效果。虽然他们认为血浆输入是一个完善且标准的治疗项目,但无论是收取费用还是试验本身,都受到外界的很多质疑。
有来自加州大学伯克利分校的研究团队对“吸血鬼疗法”提出质疑,研究负责人表示,他们的研究表明,年轻的血液本身并不能作为有效的药物。更确切地说,在年老的血液中有抑制剂,需要以扭转老化为目标。“在实验中没有任何一个情况证明,年轻的血液能改善脑神经的状况;年老的血液中似乎有脑细胞健康和生长的抑制剂,如果我们想提高记忆力的话,需要鉴定和移除它们。”
新知
人类脐带血可以增强年老小鼠的认知功能
到目前为止,仍然没有临床证据证实这一抗衰老项目是有利的。所谓的“吸血鬼疗法”,就好似泡沫一般迷人却虚幻,经不起推敲,吹弹可破。另一方面,也有研究者站出来否定年轻血液具有“返老还童”作用,力证年轻血液本身并不能作为有效的药物。更确切地说,在年老的血液中有抑制剂,需要以扭转老化为目标。
与血液相关的研究,无论是抗衰老抑或其他方向,科学家的脚步从未停歇过。不久前,一篇在线刊登于《自然》网站的论文显示,人类脐带血中的一种蛋白质可以活化年老小鼠的海马体,增强其认知功能。来自美国斯坦福大学医学院的研究者指出,在之前已经发现,注入了较年轻的血浆后,年迈小白鼠的造血干细胞得到了重新激发,能制造出更多年轻组织,让神经细胞重新开始学习,它们能更加准确地记住方位,更迅速地避开自己不喜欢的薄荷气味。而这次最新的研究,不但发现人类脐带血具有类似效果,而且还识别出了促使产生该效果的蛋白质。
像其他器官一样,大脑也面临着不可避免的机体衰老。在未来,真的可以利用宝宝的脐带血来挽救阿兹海默症老人的记忆吗?虽然最新研究只是一个初步实验,但却给人类带来了希望。研究者表示,这项新发现意味着生命初期出现的系统性因子,可能有助于活化年老组织,有助于今后开发靶向治疗老化大脑的疗法。
专家说:
“换血疗法”的益处远大于弊端
关于“换血疗法”,其实我们了解得并不多,始终停留在“血型匹配”的认识基础上。事实上,“换血”并不是一件“轻松”的事,重复增加来自于不同基因的人的血液或其他成分,不但会有免疫排斥的副作用,严重的还会导致器官衰竭。但是,对于一些严重疾病(例如自身免疫),“换血疗法”得到了美国食品药品监督管理局的批准。
中山大学附属第二医院血液科主治医师王婕妤告诉记者,所谓“换血疗法”,在临床应用最多的应该是“血浆置换”。由于血浆置换能直接和快速地清除一些直接导致疾病的因子,所以常常收到意外的疗效。“简单地说,就是利用血细胞分离机在体外将患者的血液分离成血浆和血细胞成分(红细胞、白细胞、血小板)。然后弃去含有害致病物质的血浆,用等量的置换液代替,再把血细胞成分和血浆置换液一起回输到患者的体内。”
在春天野蘑菇蓬勃生长的时候,如果有人不慎误吃了“白毒伞”,这个时候“换血疗法”就能派上用场,它适用于各种原因引起的中毒。除此之外,肾脏疾病、血液系统疾病、家族性高胆固醇血症、甲状腺危象等疾病,都可以用到“换血疗法”。
尤其对于血液系统疾病,“换血”很重要。“如自身免疫性溶血性贫血,利用血浆置换可以迅速清除患者体内的抗红细胞抗体,减轻溶血的发生。对血栓性血小板减少性紫癜,血浆置换是目前最有效的方法,它可以迅速清除患者体内的微小血栓。”王医师表示,任何疗法都存在一定风险,血浆置换的并发症有低钙血症、出血倾向、感染、过敏反应等,但结合患者具体病情,提前预防、及时对症处理,一般都能得到有效治疗。“所以说,‘换血疗法’的益处远大于其弊端。”
话题延伸
皮肤细胞可以杀死癌细胞?
再生医学的主要挑战之一,是人工创造新的血液和免疫细胞。人造血液的研究,为免疫性疾病以及其他需要输血的患者,提供了新的免疫细胞或血液来源。一般来说,我们所了解的“人造血液”,指的是通过造血干细胞在实验室中体外培养得到的红细胞。近年来,除了人工培养红细胞以外,也有科研人员致力于研发其他类型的血液替代品,例如基于血红蛋白的运氧载体。
不久前,还有新加坡的研究人员利用皮肤细胞,成功地创造出了新的小鼠血液和免疫细胞。项目团队成员之一,来自斯坦福大学医学院的研究者表示,这不仅仅是再生医学中关于新鲜血液和免疫细胞来源的问题,从基本生物学视角而言,它也十分有趣,两个非常不同的细胞可以互相转换,这是比较吸引人的。除了“制造”血液,还有来自美国萨克生物研究所的研究团队,研发出一种将普通皮肤细胞培育成人老化神经元细胞的新方法,为研究逆转时间对细胞、疾病的影响提供了最理想的材料。
当然还有更厉害的,就是利用皮肤细胞来杀死癌细胞。这一创举来自北卡罗来纳大学的药学研究人员,他们利用胶质母细胞瘤患者自身的皮肤细胞来设计个性化的治疗方案,以摆脱癌症再生,从而有效杀死胶质母细胞瘤。
让细胞“改头换面”的再生科学,在不远的未来,科学家正一步步实现。